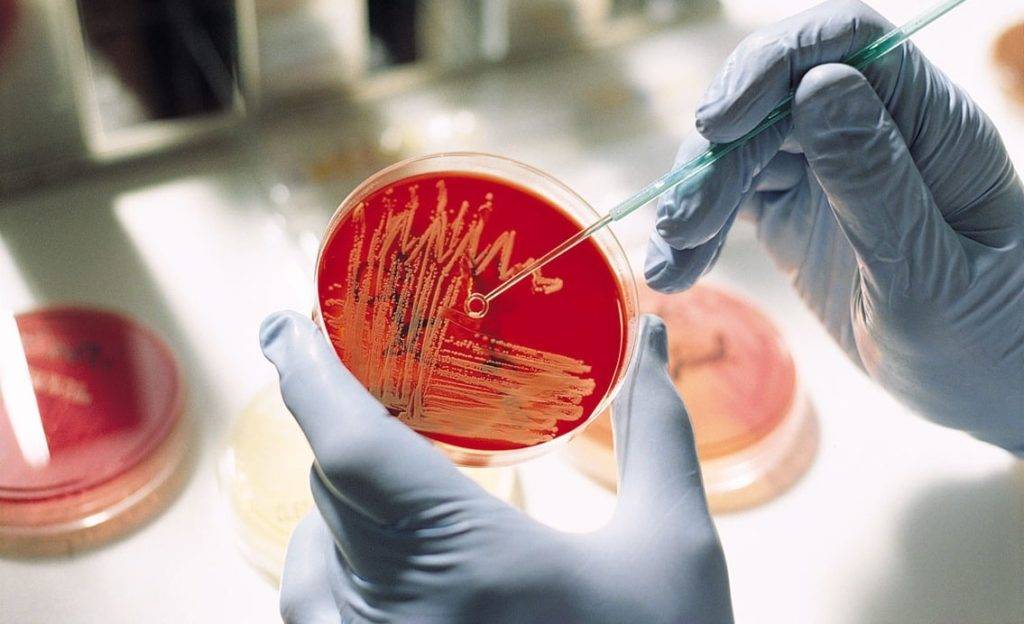

Откуда берётся у грудничка клебсиелла и чем она опасна?
Клебсиелла у грудничка в организме появляется чаще всего из внешней среды, но бывает и интранатальное (во время родов) заражение.
Характеристика микроорганизма
Клебсиелла – это бактерия, принадлежащая к семейству энтеробактерий, роду Клебсиелла. Этот род включает в себя 4 вида микроорганизмов, медицинское значение из которых имеют клебсиелла пневмонии (75-86 % всех случаев заболевания) и клебсиелла окситока (13-25% случаев).

Особенности клебсиеллы:
клебсиелла визуально представляет собой прямые палочки, по отношению к окрашиванию при бактериоскопии — грамотрицательные. В структуре бактерии имеет значение наличие капсулы и фимбрий. Капсула несёт защитную функцию: препятствует уничтожению фагоцитами и проникновению антибиотиков. Фимбрии обеспечивают присоединение к эпителию;
Благодаря капсуле клебсиелла может образовывать в организме L-формы под воздействием антибиотиков и иммунных факторов. Тогда болезнь приобретает хроническое течение.
- являются условно-патогенными микроорганизмами, т. е. входят в состав микрофлоры, населяющей кишечник, слизистые верхних дыхательных путей и кожу;
- очень устойчивы во внешней среде: сохраняются до нескольких месяцев в сточных водах, почве и воде. Хорошо переносят высокие и низкие температуры. Устойчивы к ультрафиолетовому свету и антисептическим растворам;
- очень быстро вырабатывается устойчивость к антибиотикам;
Впервые ферменты, инактивирующие антибиотики, выявили именно у клебсиеллы.
- выделяют два вида токсина (эндотоксин и экзотоксин);
- выделяют ферменты, инактивирующие лизоцим, расщепляющие стенки клеток организма. Выделяют вещества, убивающие другие бактерии;
- успешно сопротивляются бактерицидному действию крови.
Клебсиелла, обладающая таким уникальным набором приспособленческих способностей, является частым возбудителем тяжёлых внутрибольничных инфекций.
Источники заражения
Источник заражения – больной человек или бактерионоситель (например, клебсиеллу пневмонии выделяют у здоровых лиц из ротоглотки и кишечника в 5% случаях). Также может быть и животное (крупный рогатый скот, лошади, свиньи). Выделяется клебсиелла с фекалиями, с мокротой и слизистым отделяемым носоглотки, мочой и др. в зависимости от поражённого органа.
Пути передачи
Основные пути передачи клебсиеллёза:
Пищевой.
Человек употребляет в пищу заражённые продукты — мясо, молочные продукты, салаты. У младенцев имеет значение неправильное приготовление и хранение молочных смесей.
Контактно-бытовой.
Факторами передачи при этом пути может быть медицинский инструментарий в стационарных условиях.
Воздушно-капельный.

В чем опасность для ребенка?
Клебсиеллёз представляет опасность для ослабленных детей раннего возраста: недоношенных и новорождённых, родившихся в состоянии асфиксии, перенёсших травматические роды, с пороками развития, малой массой при рождении и др. Часто клебсиеллёз присоединяется к другим вирусным и бактериальным инфекциям, утяжеляя их течение.
В норме до 3 недельного возраста даже у здоровых новорождённых и недоношенных присутствует физиологическая гиппогаммаглобулинэмия. Только с 3 недели у них начинают вырабатываться иммуноглобулины класса М, а с 3 месяца -иммуноглобулины класса G. У недоношенных может быть этот период удлинён.
Клебсиелла в кишечнике у грудничка
Клебсиеллезная кишечная инфекция
Правильный диагноз не всегда удается сразу поставить, поскольку симптоматика схожа на заболевания энтеритом, энтероколитом и другими острыми заболеваниями ЖКТ.
Начало болезни бурное:
- высокая температура тела ребенка (доходит до отметки 39 C );
- рвота до 8 раз в сутки;
- сильный понос (до 15 -20 раз);
- пена и кровь в кале;
- изменяется цвет кала на зеленый;
- гнилостный запах фекалий;
- живот болезненный;
- отказ от еды;
- состояние ребенка ухудшается очень быстро;
- быстро наступает обезвоживание.
В случае, если на лицо не все перечисленные симптомы, а только некоторые, нужна консультация врача.
Как лечить
Новорожденных детей и детей с сильной интоксикацией лечат в стационаре.
Общая схема лечения направлена на:
- Назначение кишечных антисептиков (Уроксолин, Фуразолидон).
- Назначение пробиотиков (Бифиформ, Лактовит).
- Применение ферментов (Фестал, Панкреатин).
- Использование бактериофагов (Бактериофаг Клебсиелл).
Примерная схема лечения при системной инфекции.
| Препарат | Дозировка |
| Ампициллин
| 45 мг /кг; 7 — 10 дней. |
| Неомицин | 10 мг /кг; 7 дней. |
| Бактериофаг Клебсиелл
| От 1 мес. до 6 мес. – 5 мл; От 6 до 1 года – 10мл; 14 дней. |
| Бифиформ
| 1 пакет/ 3 раза в день; 5 – 10 дней. |
При своевременно начатом лечении выздоровление наступает сравнительно быстро. Для предупреждения заболевания необходимо укреплять иммунитет. Именно он является сдерживающим фактором в развитии клебсиеллы.
Диагностика Клебсиеллы у детей:
Для постановки диагноза необходимо обнаружение возбудителя или обнаружение нарастания титра антител к аутоштамму. Используют бактериологические методы исследования испражнений, рвотных масс, крови, мокроты, отделяемого из воспалительных очагов на коже и видимых слизистых оболочках, мочи. Диагностическое значение имеют выделение клебсиелл от больного в количестве 106 микробных тел и более в 1 г фекалий и снижение количества бактерий по мере выздоровления ребенка. Вспомогательную роль играет нарастание титров антител каутоштамму клебсиеллы в процессе болезни. Титры противоклебсиеллезных агглютининов колеблются от 1:20 до 1:80 или от 1:8 до 1:64.
Симптомы муковисцидоза
Специалисты выделяют несколько форм заболевания: кишечную, легочную и смешанную.
К основным симптомам заболевания обычно относят:
- отсутствие аппетита, крики и громкий плач у грудничков и новорожденных;
- вздутие живота;
- ощущение сухости во рту.
Симптомы муковисцидоза зависят от формы болезни. Муковисцидоз легких сильно снижает иммунитет, а поскольку слизистые пробки легко поражаются бактериями стафилококка или синегнойной палочки, люди постоянно страдают от повторяющихся бронхитов и пневмоний.
Основные признаки муковисцидоза легких1:
- частые респираторно-вирусные заболевания;
- постоянный приступообразный кашель с густой и плохо отделяемой мокротой;
- склонность к воспалению легких и бронхитам на фоне ОРВИ*;
- жесткое дыхание, появления свистящих хрипов при простудах и вирусных заболеваниях;
- появление одышки, признаков гипоксии;
- снижение веса, авитаминозы;
- изменение формы грудной клетки, которая приобретает вид лодочного киля, может становиться бочкообразной;
- ногтевые пластины, кончики пальцев приобретают вид барабанных палочек.
Кишечная форма муковисцидоза характеризуется ферментной недостаточностью, нарушением всасывания полезных веществ в кишечнике. В результате нехватки ферментов стул становится “жирным”, могут активно размножаться бактерии, в результате чего накапливаются газы, что приводит к выраженному метеоризму. Стул учащается, а объем каловых масс может в несколько раз превышать возрастную норму.
У детей кишечная форма муковисцидоза протекает с повышенной вязкостью слюны и сильной жаждой. Аппетит может быть снижен из-за нарушения пищеварения, постоянных болей в животе и метеоризма. С первых дней жизни ребенок может страдать кишечной непроходимостью, которая обусловлена нехваткой фермента трипсина, отвечающего за расщепление белков. В результате в тонком кишечнике происходит накопление мекония – плотной, густой массы темно-коричневого цвета. У ребенка появляются запоры и частые срыгивания, возможно возникновение рвоты. Помимо симптомов со стороны желудочно-кишечного тракта (ЖКТ) заболевание может сказываться на общем состоянии организма, поскольку качественное питание оказывает прямое влияние на развитие ребенка. Из-за нехватки полезных веществ могут появляться слабость, ломкость костей, ухудшаться состояние кожи, ногтей, волос1.
Смешанная форма заболевания характеризуется сочетанием поражения кишечника и бронхолегочной системы. Это проявляется и в симптомах: люди со смешанной формой муковисцидоза страдают от частых вирусных заболеваний, затяжного кашля и одновременно от нарушения пищеварения, метеоризма1.
Независимо от формы болезни одним из частых симптомов муковисцидоза является соленый вкус кожи больного. Это объясняется повышенным содержанием хлоридов в поте и на протяжении долгого времени являлось ключевым признаком для постановки диагноза1.
Какие методы помогут подтвердить диагноз?
Врач ставит предварительный диагноз на основании жалоб, анамнеза жизни (течение беременности, характер родов, состояние при рождении), наличии сопутствующих заболеваний, объективного осмотра. Диагноз уточняется следующими методами.
Бактериоскопическое исследование
Берут жидкости организма в зависимости от локализации патологического процесса: мокроту, мочу, фекалии, желчь и др. Мазки окрашивают и под микроскопом выявляют капсульные формы клебсиеллы.
Бактериологическое обследование
При этом обследовании производится забор и посев крови, мокроты, кала и др. на питательные среды. В результате вырастают колонии возбудителя, что позволяет определить его вид и чувствительность к антибиотикам.
С живыми культурами проводят реакцию агглютинации, фаготипирование.
Когда обнаруживается клебсиелла у грудничка в кале (например, при анализе на дисбактериоз) в количестве до 10 в третьей степени на 1 грамм кала — это не патология, и нет повода для назначения антибиотиков.
Серологические исследования
При данном обследовании сыворотки крови пациента определяют наличие специфических антител. Диагностическое значение имеет нарастание титра в динамике.
Online-консультации врачей
| Консультация маммолога |
| Консультация проктолога |
| Консультация стоматолога |
| Консультация онколога |
| Консультация гомеопата |
| Консультация детского психолога |
| Консультация ортопеда-травматолога |
| Консультация психиатра |
| Консультация диетолога-нутрициониста |
| Консультация сурдолога (аудиолога) |
| Консультация сексолога |
| Консультация специалиста банка пуповинной крови |
| Консультация оториноларинголога |
| Консультация анестезиолога |
| Консультация диагноста (лабораторная, радиологическая, клиническая диагностика) |
Новости медицины
Футбольные фанаты находятся в смертельной опасности,
31.01.2020
“Умная перчатка” возвращает силу хвата жертвам травм и инсультов,
28.01.2020
Назван легкий способ укрепить здоровье,
20.01.2020
Топ-5 салонов массажа в Киеве по версии Покупон,
15.01.2020
Новости здравоохранения
Глава ВОЗ объявил пандемию COVID-19,
12.03.2020
Коронавирус атаковал уже более 100 стран, заразились почти 120 000 человек,
11.03.2020
Коронавирус атаковал 79 стран, число жертв приближается к 3200 человек,
04.03.2020
Новый коронавирус атаковал 48 стран мира, число жертв растет,
27.02.2020
Что такое Клебсиелла у детей –
Клебсиеллезная инфекция известна также как клебсиеллез или клебсиелла (по названию возбудителя) — группа инфекционных болезней, которые вызываются условно-патогенными микроорганизмами, широко распространенными у новорожденных и детей раннего возраста.
Инфекцию распространяет заболевший взрослый/ребенок или здоровый носитель инфекции. Основным путем передачи инфекции является фекально-оральный. Также возможны такие пути как контактный и воздушно-капельный. От больных вместе с выделениями возбудитель болезни попадает во внешнюю среду. Они сохраняют жизнедеятельность при комнатной и низкой температуре. В холодильнике клебсиеллы не умирают. Также сложно их убить дезинфекционными растворами и большинством антибиотиков.
Клебсиеллы часто вызывают внутрибольничные вспышки. У детей болезнь в основном возбуждает К. pneumoniae. К ней очень чувствительны новорожденные и младенцы. Способствуют развитию заболевания гипотрофия и врожденные пороки сердца, недоношенность, ОРВИ, иммунодефицитные состояния. Клебсиеллы вызывают групповую и спорадическую заболеваемость, приблизительно равную во всех сезонах.
Какие заболевания способна вызывать клебсиелла у грудного ребенка?
Клебсиелла у новорожденных и недоношенных, а также у детей до года в целом, вызывает следующие заболевания (их можно условно разделить на первичные и вторичные):
а) первичные (заболевание развивается без видимого первичного очага):
- гастроэнтероколиты,
- пневмонии (могут быть как первичные, так и вторичные),
- пиелонефрит, инфекции мочевыводящих путей (тоже по происхождению могут быть как первичные, так и вторичные),
- раневая инфекция (уязвимы в этом отношении послеоперационные больные, а у новорождённых входными воротами может быть пупочная ранка),
- отит,
- конъюнктивит;
б) вторичные (имеется первичный очаг, инфекция распространяется вследствие бактериемии):
- менингиты, менингоэнцефалиты,
- остеомиелит,
- абсцессы различных органов (печень, лёгкие, почки, головной мозг и др.),
- сепсис.
Лечение заболеваний, вызванных клебсиеллой
Состоит из двух этапов:
а) лечение острого состояния.
Основные составляющие комплексного лечения клебсиеллёзной инфекции:
антибиотикотерапия.
У ослабленных детей раннего возраста и детей до 3 месяцев, а также во всех случаях среднетяжелого и тяжёлого состояния пациентов, её назначают, как правило, сразу.
В тяжёлых случаях длительность антибиотикотерапии составляет до 3 недель. Она может быть как с использованием одного антибиотика, так и комбинированной. Используют сочетание цефалоспоринов 3-4 поколения, аминогликозидов, карбапенемов. Начинают её сразу при подозрении на клебсиеллёзную инфекцию, корректируют после появления результатов бактериологического посева;
- инфузионная терапия. Цель –восполнить потери жидкости, снизить концентрацию токсинов в крови, восстановить питание тканей;
- сопроводительное назначение пробиотиков и противогрибковых препаратов, бактериофагов;
- коррекция иммунного статуса в тяжёлых случаях препаратами иммуноглобулинов, стимуляторов лейкопоэза. Это оправдано физиологическими особенностями иммунитета детей раннего возраста.
- симптоматическое назначение сорбентов, ферментов, жаропонижающих.
б) восстановительное лечение.
Продолжается применение пробиотиков, подключается витаминотерапия.
Подходы к лечению у новорождённых детей и детей первого года жизни
Недоношенные новорождённые и дети первого года жизни – это та категория пациентов, у которой все патологические процессы имеют склонность к быстрому прогрессированию. Им требуются определённые условия внешней среды и питания.
Поэтому основные условия успешности лечения у них следующие:
- терапия должна быть начата в первые 6 часов;
- кювезное содержание недоношенных и ослабленных новорождённых с температурой минимум 30 градусов и влажностью не ниже 80 %;
- питание грудным молоком или смесью, обогащённой бифидо- и лактобактериями (в тяжёлых состояниях через зонд), при необходимости подключают парэнтеральное питание;
- проведение ежедневной гигиенической обработки кожи, слизистых и пупочного остатка;
- строгий контроль за насыщаемостью крови кислородом. Он должен быть не менее 92%. При развитии дыхательной недостаточности, падении показателей сатурации крови и неэффективности кислородотерапии, ребёнка переводят на искусственную вентиляцию лёгких;
- увеличение интервалов введения некоторых антибиотиков и противогрибковых препаратов, учитывая возрастные особенности новорождённых и недоношенных.
Лечение клебсиеллы у детей старше года
У детей старше года клебсиеллёз может проявляться чаще всего нетяжёлыми гастроэнтероколитами, токсикоинфекциями. Их можно лечить в некоторых случаях без антибиотиков с применением сорбентов, пробиотиков и бактериофагов в домашних условиях. Но терапия должна быть только под наблюдением врача, учитывая коварность заболевания в плане утяжеления состояния.
Лечение лёгочных форм заболевания, поражение мочевыделительной системы и др. проводят в стационарных условиях.
Препарат Креон при муковисцидозе

Узнать больше
Креон – ферментный препарат, разработанный специально для поддержания пищеварения и широко применяющийся при муковисцидозе1. Креон
– единственный препарат, капсула которого содержит сотни мелких частиц – минимикросфер2. Их размер не превышает 2 мм, который зафиксирован как рекомендованный в мировых и российских научных работах3,4,5. Маленький размер частиц позволяет препарату Креон воссоздавать процесс пищеварения, каким он был задуман в организме, и тем самым справляться с неприятными симптомами. Благодаря минимикросферам Креон равномерно перемешивается с пищей в желудке и одновременно с каждой ее порцией попадает в кишечник, где уже происходит ключевой этап пищеварения и усвоения питательных веществ6. Креон разрешен детям с рождения, его капсулы удобны в применении: при необходимости их можно вскрывать и смешивать минимикросферы с пищей или соком, подбирая индивидуальную дозу6.
Также в линейке Креон есть специальная форма –
Креон Микро, выпущенная специально для лечения детей с муковисцидозом. Минимикросферы помещены во флакон россыпью, в комплекте идет мерная ложечка, которая позволяет удобно насыпать нужное количество препарата.
Подробнее о Креон Микро можно прочитать здесь.
Мнение доктора Комаровского

При нормальных условиях клебсиелла находится в организме ребенка, но ничем себя не проявляет. Она является абсолютно безопасной, живет в организме любого здорового ребенка и взрослого.
Как только произошел сбой в иммунной системе, например, после применения антибактериальных препаратов, нормальная флора кишечника изменилась.
Бифидобактерии и другие полезные бактерии стали подавленными, тормозить интенсивный рост клебсиелл некому, вот и начался их интенсивный рост. А вот это уже угроза жизни маленького ребенка. Опасность заключается в их сильном токсическом воздействии на организм грудничков.
Что может спровоцировать рост и запуск развития
- Переход с грудного вскармливания к искусственному.
- Нарушение санитарного режима и гигиены.
Лечение Клебсиеллы у детей:
Для лечения необходима правильная диета и своевременная оральная регидратация. Для лечения среднетяжелых и тяжелых форм болезни необходимы антибактериальные препараты. Врачи назначают обычно гентамицин (антибиотик группы аминогликозидов широкого спектра действия), нитрофурановые препараты, 5-НОК (препарат группы оксихинолинов).
Лечение клебсиеллезной пневмонии проводится с помощью таких препаратов как цефалоспорины, карбенициллин, левомицетин. Циркулирующие штаммы клебсиелл невозможно убить пенициллином, олеандомицином, ампициллином, оксациллином. Врачи рекомендуют прием пробиотиков при лечении клебсиеллы у детей: бифидумбактерин, полибактерин и т. д.
Профилактические мероприятия

Специфической профилактики клебсиеллёзной инфекции не существует. Иммунитет после перенесённого заболевания не приобретается, поэтому основными направлениями профилактики являются:
- соблюдение санэпидрежима в стационаре (причём касается это как персонала, так и родителей пациентов), качественная обработка инструментов и поверхностей;
- личные гигиенические навыки – мытьё рук и уход за ногтями, мытьё продуктов питания, соблюдение условий и сроков хранения пищи;
- также большую роль играет характер вскармливания грудного ребёнка;
Раннее прикладывание к груди и совместное пребывание с мамой в роддоме способствует заселению желудочно-кишечного тракта бифидо- и лактобактериями, флорой матери. В противном случае кожа и кишечник новорождённого в первую очередь колонизируется госпитальной микрофлорой.
закаливание ребёнка, достаточное пребывание на свежем воздухе, правильное введение прикормов.
Основные симптомы
Повреждающее действие на организм оказывает как сама бактерия, умеющая разрушать клетки и внедряться в стенки органов, так и её токсины, которые выделяются в процессе её жизнедеятельности и при гибели микроорганизма.
Чем младше ребёнок, тем тяжелее у него протекает заболевание.
Общие симптомы клебсиеллёза
Это:
лихорадка;
У недоношенных малышей и новорождённых первых дней жизни температурная реакция может быть невыраженной, а бывает и наоборот, гипотермия, вследствие возрастного несовершенства центра терморегуляции.
синдром интоксикации (у новорождённых — это снижение активности рефлексов, в первую очередь сосательного, вялость).
Наиболее часто у грудных детей встречается кишечная и лёгочная формы клебсиеллёза. Также характерно их одновременное сочетание.
Кишечная форма
У детей раннего возраста преобладают среднетяжёлые и тяжёлые формы гастроэнтероколитов.
Клиника у грудных детей:
- рвота и срыгивания;
- боли в животе, метеоризм;
- стул жидкий, обильный, жёлто-зелёного цвета со слизью от 5 до 20 раз/сутки;
- лихорадка;
- быстрое развитие обезвоживания;
- потеря веса.
Лёгочная форма клебсиеллёза
Она представлена бронхитом и пневмонией. Последняя имеет свои особенности:
- часто поражается одна или несколько долей лёгких, может вовлекаться плевра. Как правило, пневмония двусторонняя;
- мокроты много, но она густая, её трудно откашливать детям постарше, а в первые дни и месяцы жизни, при несформированности кашлевого рефлекса, мокрота заполняет просветы бронхов, приводя к резко выраженной дыхательной недостаточности. Аускультативно: преобладает ослабление дыхания над количеством хрипов.
Сепсис

Клебсиелла у новорожденных и недоношенных чаще вызывает поздний неонатальный сепсис, который возникает с 7 дня жизни.
Для него характерно:
- быстрое и молниеносное течение, приводит часто к бактериальному септическому шоку;
- вовлечение обязательно лёгких и кишечника, а также других органов за счёт заноса бактерий с током крови;
- клинически отмечают желтушность кожи, наличие склеремы (уплотнение подкожной клетчатки).
Поражение других органов клебсиеллой клинических особенностей не имеет, симптоматика зависит от поражённого органа.








































